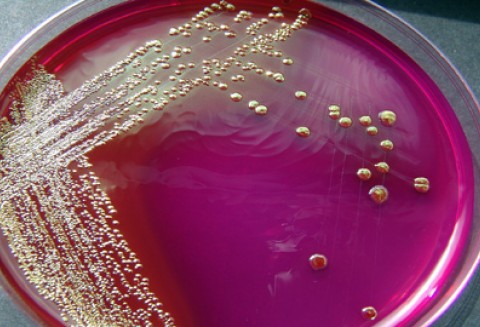
Zasady prowadzenia w Polsce monitoringu na obecność Shiga toksycznych bakterii E. coli

Wiadomości
- Artykuły|Porady|Analizy
- Biznes
- Finanse
- Gospodarz.pl
- Leśnictwo
- Poradnik Ogrodnika
- Prawo
- Produkcja roślinna
- Produkcja zwierzęca
- Targi
- Technika rolnicza
- Wiadomości giełdowe
- Z kraju
- Z życia firm
- Z życia instytucji
- - Agencja Nieruchomości Rolnych
- - Agencja Restrukturyzacji i Modernizacji Rolnictwa
- - Agencja Rynku Rolnego
- - Centrum Doradztwa Rolniczego
- - Inspekcja Jakości Handlowej Artykułów Rolno-Spożywczych
- - Inspekcja Weterynaryjna
- - Kasa Rolniczego Ubezpieczenia Społecznego
- - Krajowa Izba Biopaliw
- - Lubuska Izba Rolnicza
- - Ministerstwo Rolnictwa i Rozwoju Wsi
- - Państwowa Inspekcja Ochrony Roślin i Nasiennictwa
- - Wielkopolska Izba Rolnicza
- - Zakład Ubezpieczeń Społecznych
- Ze świata
Logowanie
W dniu 20 lipca br. Federacja Rosyjska przywraca możliwość importu z Polski warzyw świeżych wyprodukowanych w Polsce.
Zobacz inne aktualności z Kategorii:
Państwowa Inspekcja Ochrony Roślin i Nasiennictwa
Od momentu wznowienia eksportu warzyw do Federacji Rosyjskiej, oprócz dotychczas wymaganych do Federacji Rosyjskiej dokumentów, przesyłki muszą być zaopatrzone w dodatkowe dokumenty tzw. „świadectwa tymczasowe”. Podstawę do wystawiania tych dokumentów będą stanowiły wyniki badań.
Tymczasowe świadectwa na eksport świeżych warzyw na rynek Federacji Rosyjskiej będą wystawiane przez organy wojewódzkiej Państwowej Inspekcji Ochrony Roślin i Nasiennictwa, na wniosek eksportera, dla gatunków, których uprawa w miejscu produkcji, została zbadana na obecność Shiga toksycznych bakterii E. coli.
Wysyłka z towarzyszeniem świadectwa tymczasowego będzie mogła być realizowana do czasu wykrycia w Polsce Shiga toksycznych bakterii E. coli w warzywach.
Tymczasowe świadectwa poza miejscem produkcji będą wystawiane wyłącznie wtedy, gdy:
Próbka do badania na obecność Shiga toksycznych bakterii E. coli pobierana jest z partii, którą definiuje się w tym przypadku jako uprawę tego samego typu (polowa, pod folią, szklarniowa, itp.), jednego gatunku w danym cyklu produkcyjnym w jednym miejscu produkcji. Monitoring obejmuje wszystkie miejsca uprawy warzyw w Polsce, z których planowany jest eksport do Federacji Rosyjskiej.
Próbki do badań pobierane są na zlecenie producenta, zawierające następujące informacje:
- imię i nazwisko oraz adres i dane kontaktowe zleceniodawcy,
- nazwa oraz adres miejsca produkcji,
- gatunek/ki świeżych warzyw, które mają być objęte badaniem na obecność Shiga toksycznych bakterii E. coli,
- areał uprawy oraz opis sposobu uprawy (polowa, pod folią, szklarniowa, itp.) poszczególnych gatunków warzyw,
- szacunkowy (zakładany) zbiór,
- oświadczenie o pokryciu kosztów próbkobrania w celu wykrycia obecności bakterii Shiga toksycznych E. coli.
Jeżeli zleceniodawcą nie jest właściciel miejsca produkcji, do zlecenia należy załączyć pełnomocnictwo do występowania w jego imieniu.
Zlecenie na pobranie próbek do badań należy złożyć do właściwej terenowo dla miejsca produkcji jednostki Państwowej Inspekcji Ochrony Roślin i Nasiennictwa. Wykaz jednostek dostępny jest tutaj. Próbkobranie wykonują inspektorzy Państwowej Inspekcji Ochrony Roślin i Nasiennictwa. Pobrana próbka jest pakowana i zabezpieczana plombą. Czynność dokumentowana jest protokołem pobrania próbki.
Następnie próbkę we własnym zakresie, maksymalnie w ciągu 48 godz. (licząc od godziny zakończenia pobierania próby), zleceniodawca dostarcza do laboratorium Państwowego Instytutu Weterynarii – Państwowego Instytutu Badawczego w Puławach (Al. Partyzantów 57, 24-100 Puławy). Opłaty za czynności wykonywane przez inspektorów Państwowej Inspekcji Ochrony Roślin i Nasiennictwa oraz koszty dostarczenia próby do laboratorium ponosi zleceniodawca.
- wnioskodawca dostarczy wraz z wnioskiem dowód zakupu warzyw w danym miejscu produkcji oraz,
- gdy inspektor wystawiający dokument uzyska stosowne potwierdzenie, w oparciu o dane przechowywane przez Państwową Inspekcję Ochrony Roślin i Nasiennictwa, że uprawa gatunku, którego dotyczy wniosek, była w miejscu produkcji poddana badaniu na obecność Shiga toksycznych bakterii E. coli w ramach opisanego monitoringu.
źródło: http://piorin.gov.pl/
Tagi powiązane z tym artykułem:
Pliki do pobrania
Instrukcja wypełniania wniosku o dopłaty do zużytego materiału siewnego DOPŁATY 2007 DEMO
Instrukcja obsługi aplikacji ELF
DOPŁATY 2007 DEMO
Instrukcja obsługi aplikacji ELF
Tematycznie podobne wiadomości
-
Kategoria: Trzoda chlewna
Spadek eksportu wieprzowiny z Unii Europejskiej (styczeń-listopad 2012)
2013-01-29,czytaj więcej
-
Kategoria: Hodowla ryb
ARiMR prowadzi cztery nabory wniosków o pomoc w ramach PO RYBY 2007 - 2013
2013-01-29,czytaj więcej
-
Kategoria: Dotacje i dopłaty
ELF - aplikacja do wypełniania i drukowania wniosku o dopłaty do materiału siewnego [pobieralnia]
2013-01-29,czytaj więcej
-
Kategoria: Z kraju
Wzrost wydatków na wódkę w Polsce w 2013 roku
2013-01-25,czytaj więcej
-
Kategoria: Warzywa
Rynek warzyw w Polsce (17-24.01.2013)
2013-01-25,czytaj więcej
Komentarze do wiadomości
 Nie ma żadnych komentarzy! Możesz być pierwszą osobą, która skomentuje tę wiadomość. Komentarze mogą zamieszczać tylko zarejestrowani użytkownicy.
Jeśli nie masz jeszcze konta zarejestruj się.
Nie ma żadnych komentarzy! Możesz być pierwszą osobą, która skomentuje tę wiadomość. Komentarze mogą zamieszczać tylko zarejestrowani użytkownicy.
Jeśli nie masz jeszcze konta zarejestruj się.
Publikowane komentarze są prywatnymi opiniami użytkowników portalu. Gospodarz.pl nie ponosi odpowiedzialności za treść opinii. Dodając komentarz akceptujesz regulamin serwisu.
Ze świata
Rola, kształt i znaczenie Wspólnej Polityki Rolnej [video]
W coraz większym stopniu przedłużają się negocjacje w sprawie rozdysponowania finansów unijnych na kolejne 6 lat. W oczekiwaniu na rezultaty prowadzonych konsultacji zapraszam do obejrzenia krótkiego materiału video traktującego o znaczeniu WPR dla rolnictwa oraz jej kształcie na najbliższe lata. czytaj więcej
Z kraju
Biznes
Finanse
Ambitne cele prezydencji Irlandii w zakresie reformy Wspólnej Polityki Rolnej
Od 2013 roku w Polsce zwiększył się zakres kontroli tzw. wymogów wzajemnej zgodności w gospodarstwach rolnych (cross compliance - obszar C)
W 2012 roku rynek w branży leasingowej zwolnił. Wyraźny wzrost leasingu maszyn rolniczych i maszyn dla przemysłu spożywczego
ELF - aplikacja do wypełniania i drukowania wniosku o dopłaty do materiału siewnego [pobieralnia]

Dodaj do schowka
Dodaj do schowka Śledziku
Śledziku Facebooku
Facebooku







